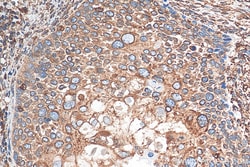
Calnexin Rabbit Recombinant Antibody, Proteintech:Antibodies:Primary Antibodies

missing translation for 'onlineSavingsMsg'
Learn More
Learn More
Calnexin Rabbit Recombinant Antibody, Proteintech
Rabbit Recombinant Antibody
129.00€ - 399.00€
Specifica
| Antigene | Calnexin |
|---|---|
| Clone | 3K18 |
| Concentrazione | 1000 μg/mL |
| Applicazioni | Western Blot, Immunohistochemistry, Immunocytochemistry/Immunofluorescence, ELISA |
| Classificazione | Recombinant Monoclonal |
| Codice del prodotto | Marca | Quantità | Prezzo | Quantità e disponibilità | |||||
|---|---|---|---|---|---|---|---|---|---|
| Codice del prodotto | Marca | Quantità | Prezzo | Quantità e disponibilità | |||||
|
30235038
|
Proteintech
81938-1-RR-20UL |
20 μL |
 149.00€ 129.00€ / 20µL Risparmia 20.00€ 13% Sconto |
Effettua il login per acquistare questo articolo Hai bisogno di un conto web ? Registrati oggi stesso! | |||||
|
30233548
|
Proteintech
81938-1-RR-100UL |
100 μL |
 439.00€ 399.00€ / 100µL Risparmia 40.00€ 9% Sconto |
Effettua il login per acquistare questo articolo Hai bisogno di un conto web ? Registrati oggi stesso! | |||||
Descrizione
The Calnexin antibody from Proteintech is a rabbit recombinant antibody generated with recombinant protein of human Calnexin. This antibody recognizes human, mouse, rat antigen. The Calnexin antibody has been validated for the following applications: WB, IHC, IF/ICC, ELISA analysis.Specifica
| Calnexin | |
| 1000 μg/mL | |
| Recombinant Monoclonal | |
| Liquid | |
| RUO | |
| 821 | |
| Recombinant Protein | |
| Primary | |
| Store at -20°C. Stable for one year after shipment. |
| 3K18 | |
| Western Blot, Immunohistochemistry, Immunocytochemistry/Immunofluorescence, ELISA | |
| Unconjugated | |
| Rabbit | |
| Human, Mouse, Rat | |
| CNX; FLJ26570; IP90; P90 | |
| IgG | |
| Protein A purification | |
| Recombinant Antibody |
Individuate un'opportunità di miglioramento?Condividi una correzione di contenuto
Correzione del contenuto del prodotto
Fornite il vostro feedback sul contenuto del prodotto compilando il modulo sottostante.
Titolo del prodotto